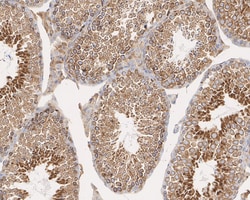
Invitrogen LNP Recombinant Mouse Monoclonal Antibody (11-1-R) 100 &mu;L;

missing translation for 'onlineSavingsMsg'
Learn More
Learn More
Invitrogen™ LNP Recombinant Mouse Monoclonal Antibody (11-1-R)


Mouse Recombinant Monoclonal Antibody
Brand: Invitrogen™ MA556453
This item is not returnable.
View return policy
Description
LNP Recombinant Monoclonal Antibody for Western Blot, IHC (P)
LNP (LNPK) is an endoplasmic reticulum (ER)-shaping membrane protein that plays a role in determining ER morphology. It is involved in the stabilization of nascent three-way ER tubular junctions within the ER network and may play a role as a curvature-stabilizing protein within the three-way ER tubular junction network. LNP is involved in central nervous system development and may be involved in limb development.
Specifications
| LNP | |
| Recombinant Monoclonal | |
| 1.075 mg/mL | |
| PBS with 0.1% BSA, 40% glycerol and 0.05% sodium azide; pH 7.4 | |
| Q7TQ95, Q9C0E8 | |
| LNP, LNPK | |
| Recombinant protein within mouse LNP aa 198-425/425. | |
| 100 μL | |
| Primary | |
| Human, Mouse, Rat | |
| Antibody | |
| IgG1 |
| Immunohistochemistry (Paraffin), Western Blot | |
| 11-1-R | |
| Unconjugated | |
| LNPK | |
| 2310011O18Rik; 4921514L11Rik; 9530051D01Rik; AI666268; Endoplasmic reticulum junction formation protein lunapark; ER junction formation factor lunapark; Kiaa1715; limb and neural patterns; LNP; LNP1; Lnpk; lunapark; lunapark, ER junction formation factor; protein lunapark; protein ulnaless; Ul; Uln; ulnaless | |
| Mouse | |
| Protein A | |
| RUO | |
| 362151, 69605, 80856 | |
| Store at 4°C short term. For long term storage, store at -20°C, avoiding freeze/thaw cycles. | |
| Liquid |
Product Content Correction
Your input is important to us. Please complete this form to provide feedback related to the content on this product.
Product Title
Spot an opportunity for improvement?Share a Content Correction